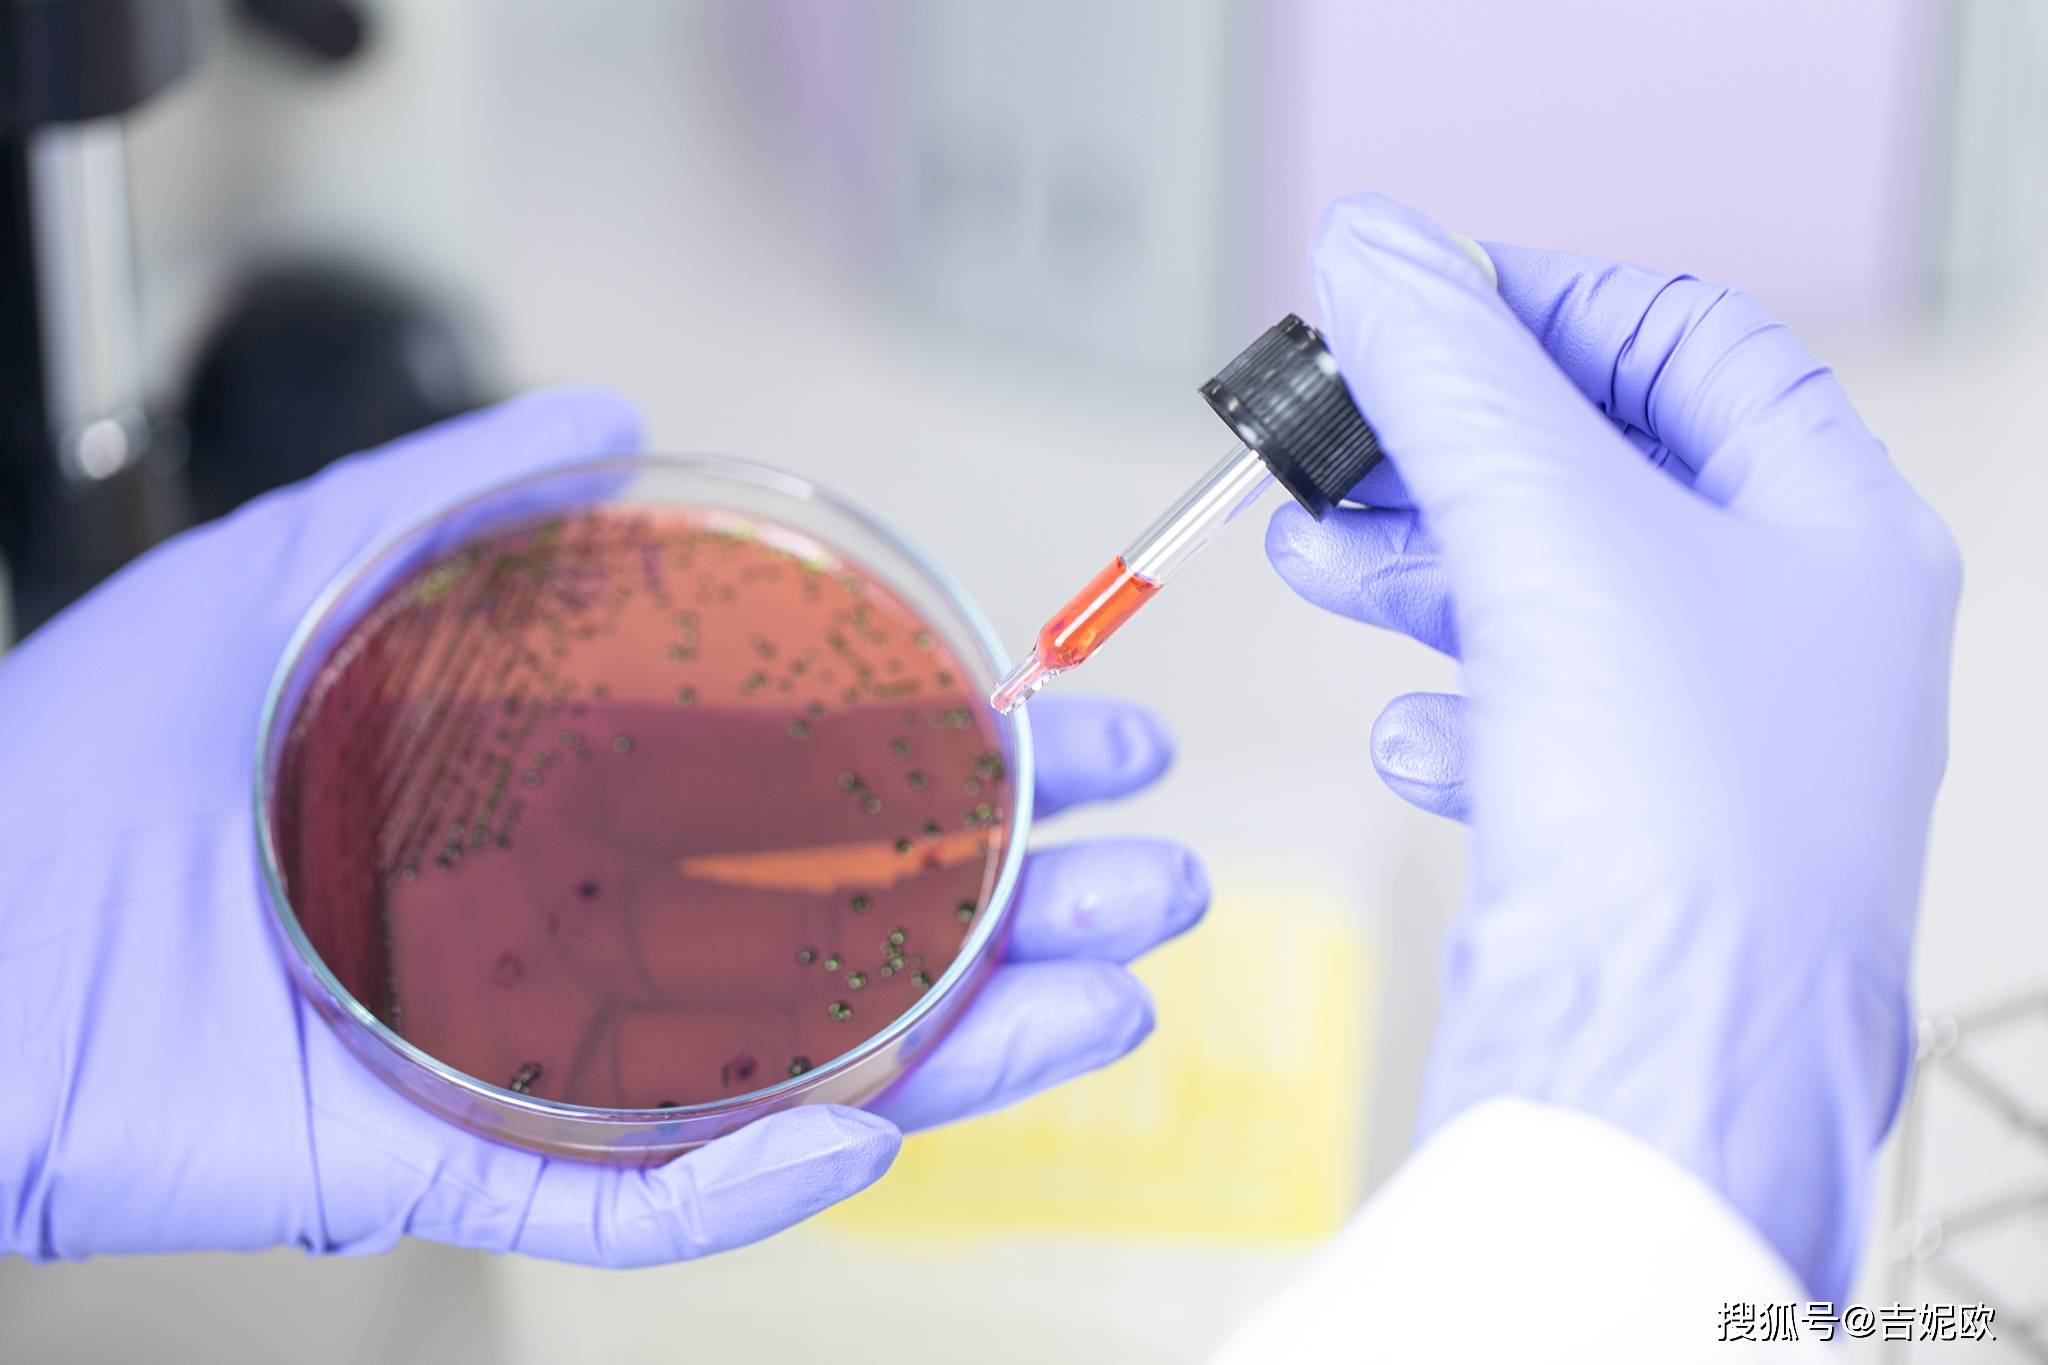
THLE 2 ATCC Hela Chang

If you are having a hard time accessing the Atcc Hela page, Our website will help you. Find the right page for you to go to Atcc Hela down below. Our website provides the right place for Atcc Hela.
.jpg?w=186)

YouTube quot YouTube quot Android YouTube
https://support.google.com › youtube › answer
YouTube YouTube

YouTube Android YouTube
https://support.google.com › youtube › answer
YouTube Google YouTube

YouTube Android YouTube
https://support.google.com › youtube › answer
YouTube Google Google YouTube


Thank you for visiting this page to find the login page of Atcc Hela here. Hope you find what you are looking for!